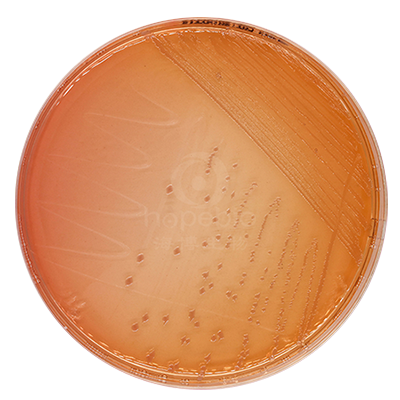
产品细节图片2

万千商家帮你免费找货
0 人在求购买到急需产品
- 详细信息
- 询价记录
- 文献和实验
- 技术资料
- 保存条件:
请置于阴凉干燥处保存
- 保质期:
三个月
- 英文名:
MacConkey Agar
- 库存:
100
- 供应商:
青岛海博生物
- 规格:
10个/包
用途:用于肠道致病菌的选择性分离、培养。
检验原理:
利用胆盐来抑制革兰氏阳性细菌的生长;利用乳糖发酵,中性红的颜色可把分解乳糖和不分解乳糖的细菌区分开。志贺氏菌呈无色菌落,半透明,光滑,湿润,圆形,边缘整齐或不齐。
麦康凯培养基上的细菌菌落特征:
| |
|
|
| 麦康凯琼脂培养基 大肠埃希氏菌ATCC25922 |
麦康凯琼脂培养基 福氏志贺氏菌CMCC51572 |
麦康凯琼脂培养基 痢疾志贺氏菌CMCC51105 |
麦康凯琼脂平板9cm微生物灵敏度试验:
接种以下质控菌株,放置36±1℃需氧培养20-24小时。
注:回收率计算时,用TSA琼脂做对照培养基。
风险提示:丁香通仅作为第三方平台,为商家信息发布提供平台空间。用户咨询产品时请注意保护个人信息及财产安全,合理判断,谨慎选购商品,商家和用户对交易行为负责。对于医疗器械类产品,请先查证核实企业经营资质和医疗器械产品注册证情况。
- 作者
- 内容
- 询问日期
文献和实验埃希菌属的培养特性:兼性厌氧菌,营养要求不高,在普通营养肉汤中呈浑浊生长。普通营养琼脂上呈灰白色的光滑型菌落。血琼脂平板上,少数菌株产生溶血环。在伊红美蓝琼脂上,由于发酵乳糖,医|学教育网搜集整理菌落呈蓝紫色并有金属光泽。麦康凯和SS琼脂中的胆盐对其有抑制作用,耐受菌株能生长并形成粉红色菌落。
埃希菌属的培养特性: 兼性厌氧菌,营养要求不高,在普通营养肉汤中呈浑浊生长。普通营养琼脂上呈灰白色的光滑型菌落医学教育网搜|集整理。血琼脂平板上,少数菌株产生溶血环。在伊红美蓝琼脂上,由于发酵乳糖,菌落呈蓝紫色并有金属光泽。麦康凯和SS琼脂中的胆盐对其有抑制作用,耐受菌株能生长并形成粉红色菌落。
埃希菌属的培养特性是检验主管技师考试要求掌握的内容,医学教育网搜集整理相关内容供大家参考。 埃希菌属的培养特性:兼性厌氧菌,营养要求不高,在普通营养肉汤中呈浑浊生长。普通营养琼脂上呈灰白色的光滑型菌落。血琼脂平板上,少数菌株产生溶血环。在伊红美蓝琼脂上,由于发酵乳糖,菌落呈蓝紫色并有金属光泽。麦康凯和SS琼脂中的胆盐对其有抑制作用,耐受菌株能生长并形成粉红色菌落。
技术资料暂无技术资料 索取技术资料